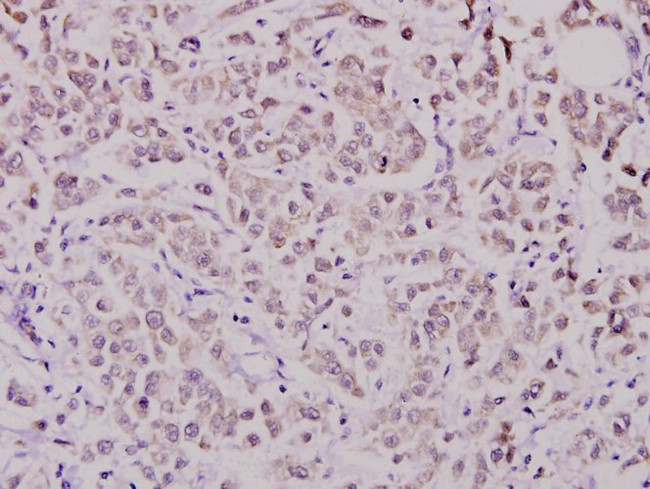
WAVE1 Antibody in Immunohistochemistry (Paraffin) (IHC (P))

Search
Invitrogen
WAVE1 Polyclonal Antibody
{{$productOrderCtrl.translations['antibody.pdp.commerceCard.promotion.promotions']}}
{{$productOrderCtrl.translations['antibody.pdp.commerceCard.promotion.viewpromo']}}
{{$productOrderCtrl.translations['antibody.pdp.commerceCard.promotion.promocode']}}: {{promo.promoCode}} {{promo.promoTitle}} {{promo.promoDescription}}. {{$productOrderCtrl.translations['antibody.pdp.commerceCard.promotion.learnmore']}}


Please note: We are reviewing Western blot images included in the antibody testing data in our catalog, including those provided by third parties. Unless expressly labeled or annotated as “raw-unedited”, Western blot images included in the antibody testing data in our catalog may have been edited, optimized or otherwise adjusted for presentation.
产品信息
PA5-75194
种属反应
宿主/亚型
分类
类型
抗原
偶联物
形式
浓度
规格
纯化类型
保存液
内含物
保存条件
运输条件
RRID
产品详细信息
The antibody was affinity-purified from rabbit antiserum by affinity-chromatography using epitope-specific immunogen and the purity is > 95% (by SDS-PAGE).
靶标信息
WASP (for Wiskott-Aldrich syndrome protein) and N-WASP are downstream effectors of Cdc42 that are implicated in actin polymerization and cytoskeletal organization. The WASP family also includes VASP (vasodilator-stimulated phosphoprotein) and Mena (for mammalian enabled protein), which accumulate at focal adhesions and are also involved in the regulation of the actin cytoskeleton. The WAVE proteins are related to the WASP family proteins and are likewise involved in mediating actin reorganization downstream of the Rho family of small GTPases. The two protein homologs WAVE1 and WAVE2 specifically regulate membrane ruffling by inducing the formation of actin filament clusters in response to GTP binding and activating Rac. The WAVE proteins mediate this actin polymerization by cooperating with the Arp2/3 complex, a nucleation core, and thereby promoting the formation of actin filaments. WAVE1, which is also designated SCAR (for suppressor of cAR), is expressed primarily in the brain, while WAVE2 is widely expressed with the expression highest in peripheral blood leukocytes. WAVE3 forms a multiprotein complex that links receptor kinases and actin. Binding to actin occurs through a C-terminal verprolin homology domain in all family members. The multiprotein complex serves to tranduce signals that involve changes in cell shape, motility or function.
仅用于科研。不用于诊断过程。未经明确授权不得转售。
篇参考文献 (0)
生物信息学
蛋白别名: Actin-binding protein WASF1; Protein WAVE-1; Verprolin homology domain-containing protein 1; WAS protein family; WASP family 1; WASP family protein member 1; Wiskott-Aldrich syndrome protein family member 1
基因别名: AI195380; AI838537; KIAA0269; Scar; SCAR1; WASF1; WAVE; WAVE-1; WAVE1
UniProt ID: (Rat) Q5BJU7, (Mouse) Q8R5H6
Entrez Gene ID: (Rat) 294568, (Mouse) 83767